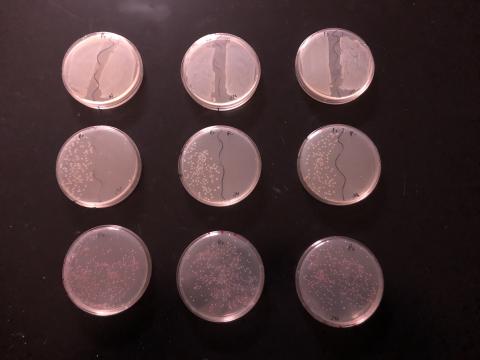

Lab 5a Results
Lab 5a Expected Results

Below are pictures of the expected results for Lab 5a.
Starting from the top row of plates; these are LB plates. Notice that the growth on the LB plates are positive on both the P+ and P- sides.
The next row of plates; these are LB/AMP plates. Notice that the growth on the LB/AMP plates are positive on only the side labeled P+.
The last row of plates; these are LB/AMP/ARA plates. Notice that on the LB/AMP/ARA plates has pink colonies.